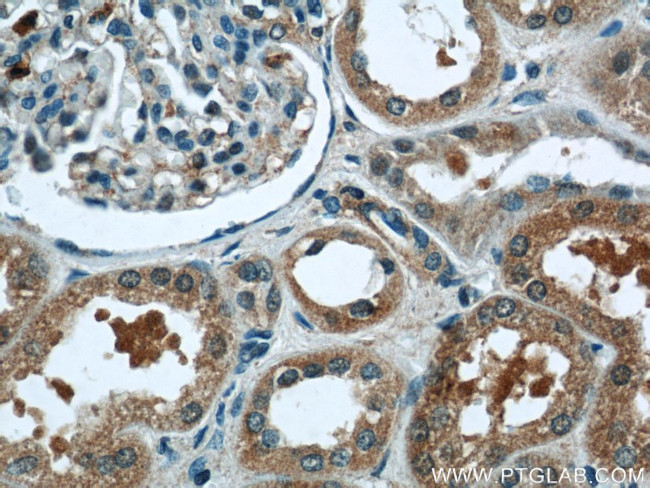
PANX1 Antibody in Immunohistochemistry (Paraffin) (IHC (P))
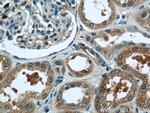
PANX1 Antibody in Immunohistochemistry (Paraffin) (IHC (P))

Search
Proteintech
PANX1 Polyclonal Antibody
{{$productOrderCtrl.translations['antibody.pdp.commerceCard.promotion.promotions']}}
{{$productOrderCtrl.translations['antibody.pdp.commerceCard.promotion.viewpromo']}}
{{$productOrderCtrl.translations['antibody.pdp.commerceCard.promotion.promocode']}}: {{promo.promoCode}} {{promo.promoTitle}} {{promo.promoDescription}}. {{$productOrderCtrl.translations['antibody.pdp.commerceCard.promotion.learnmore']}}
产品信息
12595-1-AP
种属反应
已发表种属
宿主/亚型
分类
类型
抗原
偶联物
形式
浓度
规格
纯化类型
保存液
内含物
保存条件
运输条件
产品详细信息
Immunogen sequence: FWRFAAAPH ICSDLKFIME ELDKVYNRAI KAAKSARDLD MRDGACSVPG VTENLGQSLW EVSESHFKYP IVEQYLKTKK NSNNLIIKYI SCRLLTLIII LLACIYLGYY FSLSSLSDEF VCSIKSGILR NDSTVPDQFQ CKLIAVGIFQ LLSVINLVVY VLLAPVVVYT LFVPFRQKTD VLKVYEILPT FDVLHFKSEG YNDLSLYNLF LEENISEVKS YKCLKVLENI KSSGQGIDPM LLLTNLGMIK MDVVDGKTPM SAEMREEQGN QTAELQGMNI DSETKANNGE KNARQRLLDS SC (126-426 aa encoded by BC016931)
靶标信息
The pannexin gene family encodes a second class of putative gap junction proteins and are highly conserved in invertebrates and mammals. Pannexins (Panx) are four-pass transmembrane proteins that oligomerize to form large pore ion and metabolite-permeable channels. Pannexin-1 (PANX1) and Pannexin-3 are closely related, while Pannexin-2 is a more distant relation. PANX1 is a transmembrane protein that forms a mechanosensitive ATP-permeable channel between adjacent cells and in the endoplasmic reticulum. PANX1 may play a role as a Ca2+ -leak channel to regulate ER Ca2+ homeostasis and regulates neural stem and progenitor cell proliferation.
仅用于科研。不用于诊断过程。未经明确授权不得转售。
生物信息学
蛋白别名: innexin; Pannexin-1; PANX1; unnamed protein product
基因别名: AI847747; MRS1; OOMD7; OZEMA7; PANX1; PX1; UNQ2529; UNQ2529/PRO6028
UniProt ID: (Human) Q96RD7, (Mouse) Q9JIP4
Entrez Gene ID: (Human) 24145, (Mouse) 55991